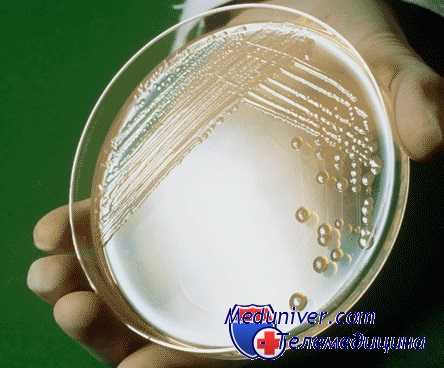
мезентериальный тромбоз

Инфекционные болезни и тромбоз мезентериальных сосудов. Частота мезентериального тромбоза
Добавил пользователь Morpheus Обновлено: 31.12.2025
Обструкция портальной вены приводит к нарушению портального кровотока. Она может быть внепеченочной (вследствие тромбоза или врожденной атрезии портальной вены) или внутрипеченочной (микроваскулярная обструкция портальной вены при шистосоматозе).
Тромбоз портальной вены (обструкция портальной вены тромбом или опухолью) может локализоваться в различных ее отделах, в том числе и в селезеночных ветвях.
Основными причинами тромбоза портальной вены или селезеночной вены являются: цирроз печени , опухоли, панкреатиты , полицитемии, сепсис. У 50% пациентов причины возникновения тромбоза портальной вены установить не удается.
При остро возникшем тромбозе внезапно появляется боль в животе, тошнота. Нередко начальным симптомом является желудочно-кишечное кровотечение. В дальнейшем развивается асцит , в ряде случаев геморрагический. При вовлечении в процесс селезеночной вены отмечается боль в левом подреберье и быстрое увеличение селезенки.
При циррозе печени наблюдается хроническое течение тромбоза портальной вены. Он развивается длительно (от нескольких месяцев до нескольких лет).
Тромбоз портальной вены приводит к портальной гипертензии и желудочно-кишечным кровотечениям.
Диагноз основан на результатах допплеровского ультразвукового исследования, КТ и МРТ органов брюшной полости, ангиографии.
Лечение заключается в предупреждении возникновения желудочно-кишечных кровотечений, назначении антикоагулянтов и тромболитических препаратов.
Этиология и патогенез
Закрытие просвета (обструкция) портальной вены приводит к нарушению портального кровотока. Такое закрытие может быть вызвано закупоркой портальной вены тромбом. Обструкция и тромбоз портальной вены могут располагаться в различных ее отделах, но выше уровня слияния селезеночной и верхней брыжеечной вен.
- Причины развития тромбоза портальной вены
У 50% пациентов причины возникновения тромбоза портальной вены установить не удается.
Причины врожденного характера.
- Коагулопатии.
- Мутация гена протромбина (G20210).
- Мутация фактора V Лейдена.
- Дефицит протеина С .
- Дефицит протеина S.
- Дефицит антитромбина II.
Причины приобретенного характера.
- Цирроз печени .
- Системная красная волчанка.
- Ожоги.
- Злокачественные новообразования (холангиокарцинома, карцинома желудка и поджелудочной железы).
- Миелопролиферативные заболевания.
- Беременность/послеродовый период.
- Прием оральных контрацептивов.
- Травмы.
- Ятрогенная катетеризация пупочной вены.
- Абдоминальный сепсис.
- Хронический панкреатит .
- Инфекционные заболевания (аппендицит, дивертикулит, перинатальный омфалит, гнойный холангит).
- Трансплантация печени (тромбоз портальной вены осложняет течение послеоперационного периода в 5-15% случаев).
У взрослых тромбоз портальной вены в 24-32% случаев вызывается циррозом печени .
У 21-24% больных с обструкцией портальной вены обнаруживаются злокачественные опухоли (в большинстве случаев гепатоцеллюлярная карцинома и карцинома поджелудочной железы). Они оказывают компрессионное или прямое воздействие на портальную вену и приводят к формированию гиперкоагуляционного статуса.
Инфекционные заболевания брюшной полости также могут вызывать обструкцию и тромбоз портальной вены у взрослых пациентов, особенно при бактериемии возбудителем Bacteroides fragilis.
Миелопролиферативные заболевания, а также врожденные и приобретенные коагулопатии приводят к обструкции и тромбозу портальной вены в 10-12% случаев.
Венозный застой, вызванный резистентностью печеночной ткани, которая наблюдается при циррозе печени, также может провоцировать возникновение тромбоза портальной вены.
Портальная вена образуется слиянием селезеночной и верхней брыжеечной вен. Места обструкции и тромбоза локализуются выше уровня этого слияния.
При циррозе печени и злокачественных опухолях процесс тромбирования портальной вены начинается в ее внутрипеченочном отделе и распространяется на внепеченочную часть.
При тромбозе, вызванном другими причинами, патологический процесс возникает в месте начала портальной вены.
Тромбоз селезеночной вены, который наблюдается при хроническом панкреатите , также распространяется и на портальную вену.
Обструкция портальной вены не нарушает функцию печени до тех пор, пока у пациента не возникнет заболевание печени (например, цирроз). Это происходит за счет компенсаторного усиления кровотока в системе печеночных артерий.
Среднее время формирования коллатерального кровообращения составляет 5 недель; при остром тромбозе - 12 дней. При этом риск возникновения кровотечения из варикозно-расширенных вен пищевода, желудка и кишечника повышается. Развивается асцит .
Кавернозная мальформация портальной вены (т.е. развитие перипортальных коллатералей) возникает при длительном течении тромбоза портальной вены в результате разрастания мелких сосудов вокруг места тромбоза. Скорость кровотока по этим сосудам составляет 2-7 см/сек. На снимках, выполненных в ходе эндоскопической ретроградной холангиогепатографии, у пациентов с портальной гипертензией кавернозная трансформация портальной вены выглядит как губкоподобная масса, расположенная под печенью. Аналогичные данные можно получить и у пациентов с гемангиосаркомой поджелудочной железы, и у больных псевдохолангиосаркомой. После выполнения трансюгулярного внутрипеченочного портосистемного шунтирования и устранения явлений портальной гипертензии кавернозная мальформация портальной вены на снимках не визуализируется.
Эпидемиология
Обструкция портальной вены диагностируется у 5-18% пациентов с циррозом печени .
Частота возникновения тромбоза портальной вены у пациентов с гепатоцеллюлярной карциномой составляет 30%; у больных циррозом печени - 5%.
Смерть при обструкции портальной вены обусловлена возникновением кровотечений из варикозно-расширенных вен желудка, пищевода и кишечника.
Риск появления кровотечений в течение 2 лет у пациентов без цирроза печени составляет 0,25%, а смертность - 5%. Аналогичные показатели у больных циррозом печени: 20-30% и 30-70% соответственно.
Клиническая картина
Клинические критерии диагностики
асцит, кровотечения из варикозно расширенных вен пищевода, портальная гипертензия, печеночная недостаточность
Cимптомы, течение
Течение тромбоза портальной вены может быть острым и хроническим.
В некоторых случаях острая фаза заболевания может протекать бессимптомно. Для хронического течения тромбоза портальной вены характерно длительное развитие клинической симптоматики (от нескольких месяцев до нескольких лет).
У пациентов внезапно появляются боли в правом верхнем квадранте живота; беспокоит тошнота; может повышаться температура тела. Развивается асцит .
Могут возникать желудочно-кишечные кровотечения.
В хронической фазе тромбоз портальной вены может манифестировать симптомами портальной гипертензии . В 90% случаев в период 4-12 лет от начала формирования тромбоза возникает кровотечение из варикозно-расширенных вен пищевода, желудка и кишечника.
При наличии цирроза печени и признаков печеночной недостаточности , у пациентов с тромбозом портальной вены наблюдаются симптомы печеночной энцефалопатии, развивается асцит . При этом асцит и печеночная энцефалопатия - редкие осложнения, если у больного нет цирроза печени. Если у пациента имеются злокачественные новообразования, то симптомами тромбоза портальной вены являются: асцит , анорексия, снижение массы тела, боли в эпигастральной области или в верхнем правом квадранте живота.
Диагностика
- Рентгенография органов брюшной полости.
С помощью этого исследования можно выявить гепатоспленомегалию, варикозно-расширенные непарную, паравертебральные вены и варикозно-расширенные вены пищевода.
Кавернозная мальформация портальной вены (т.е. развитие перипортальных коллатералей) возникает при длительном течении тромбоза портальной вены в результате разрастания мелких сосудов вокруг места тромбоза. Скорость кровотока по этим сосудам составляет 2-7 см/сек. На снимках, выполненных в ходе эндоскопической ретроградной холангиогепатографии, у пациентов с портальной гипертензией кавернозная мальформация портальной вены выглядит как губкоподобная масса, расположенная под печенью. Аналогичные данные можно получить и у пациентов с гемангиосаркомой поджелудочной железы, и у больных псевдохолангиосаркомой. После выполнения трансюгулярного внутрипеченочного портосистемного шунтирования и устранения явлений портальной гипертензии кавернозная трансформация портальной вены на снимках не визуализируется.
Чувствительность эндоскопического УЗИ для диагностики тромбоза портальной вены составляет 81%, специфичность - 93%. Тромб в портальной вене визуализируется как эхогенное образование в просвете портальной вены. Недавно сформировавшийся тромб может быть гипо- или анэхогенным.Допплеровское ультразвуковое исследование.
Чувствительность метода составляет 70-90%, специфичность - 99%. Ложно-позитивные результаты можно получить в 9% случаев у пациентов с циррозом печени из-за турбулентного кровотока в портальной вене.
В ходе этого исследования можно обнаружить: кавернозную мальформацию портальной вены, шунты, спленоренальные и портосистемные коллатерали, геатоцеллюлярную карциному , метастазы в печень , цирроз печени , опухоли поджелудочной железы.
В 38% случаев у пациентов с тромбозом портальной вены диаметр сосуда более 15 мм. При развитии портального флебита стенки сосуда утолщены, а просвет сужен. Можно выявить кальцифицированные тромбы.
Компьютерная томография - КТ.
Чувствительность метода составляет 65-85%.
С помощью этого исследования можно выявить тромб в просвете портальной вены, нарушения структуры печени, варикозно-расширенные вены пищевода и желудка.
При комбинировании этого метода с допплеровским ультразвуковым исследованием можно обнаружить обструкцию портальной вены.
Проводится также КТ-портография. На снимках тромбоз портальной вены визуализируется как участок пониженной плотности в просвете портальной вены, периферия которого определяется как зона повышенной плотности. Кроме того, у пациентов с портальной гипертензией можно обнаружить сеть коллатералей, варикозно-расширенные вены.
Магнитнорезонансная томография - МРТ.
Чувствительность, специфичность и точность метода составляет 100, 98 и 99% соответственно. С помощью этого исследования можно изучать состояние паренхимы печени (с целью выявления злокачественных опухолей); выявлять нарушения кровотока в системе портальной и печеночной вен (с целью решения вопроса о целесообразности хирургического лечения и для выбора необходимого метода). Кроме того, можно обнаружить коллатеральное кровообращение. Можно отдифференцировать причины тромбоза: кровяной тромб дает более интенсивное окрашивание при введении гадолиния, чем обструкция сосуда опухолью.
Остро возникший тромб (давностью менее 5-недельной) визуализируется как участок повышенной плотности в просвете портальной вены.
Ангиография.
Как правило, перед проведением шунтирующих операций или трансплантации печени, выполняются артериальная портография или спленопортография. С помощью этих методов можно оценить операбельность опухолей печени и поджелудочной железы. Кроме того, они незаменимы перед выполнением транскатетерной эмболизации опухолей или хемоэмболизации гепатоцеллюлярной карциномы .
Биопсия печени.
При наличии цирроза и злокачественных новообразований у пациента гистологическая картина биоптатов печени характерна для этих заболеваний.
У пациентов с тромбозом или обструкцией портальной вены, не страдающих циррозом и онкозаболеваниями, в биоптатах печени может не быть специфических изменений.
Лабораторная диагностика
У больных циррозом печени наблюдается уменьшение количества тромбоцитов . Развитие анемии или других цитопений характерно для поздних стадий заболевания. При гиперспленизме развивается панцитопения (анемия, лейкопения, тромбоцитопения).
Выполняется для диагностики врожденных коагулопатий (мутация гена протромбина (G20210), мутация фактора V Лейдена, дефицит протеина С , дефицит протеина S , дефицит антитромбина II), которые могут стать причиной развития тромбоза портальной вены.
У пациентов с циррозом печени наблюдается снижение протромбинового индекса (отношение стандартного протромбинового времени к протромбиновому времени у обследуемого больного, выраженное и процентах). Референтные значения: 78 - 142 %.
У пациентов без цирроза печени и злокачественных новообразований может отмечаться незначительное увеличение показателей функции печени.
Дифференциальный диагноз
Дифференциальный диагноз тромбоза портальной вены проводится со следующими заболеваниями:
Инфекционные болезни и тромбоз мезентериальных сосудов. Частота мезентериального тромбоза
Мы наблюдали 78 больных, госпитализированных с диагнозом пищевой токсикоинфекции в тяжелом состоянии, у которых был диагностирован тромбоз мезентериальных сосудов. Половина больных были старше 70 лет. Большинство наблюдаемых страдали заболеваниями сердечно-сосудистой системы. Боль в области живота и рвота отмечалась у всех больных, диарея — у 89,7 %, и лишь у некоторых из них в кале имелась примесь слизи и крови.
При патологоанатомическом вскрытии тромбоз верхней брыжеечной артерии выявлен у 65 больных (83,3 %), нижней брыжеечной артерии — у 6 (7,7 %), верхней и нижней конечности одновременно — у 6 больных (7,7 %), брыжеечных вен — у 1 (1,3 %), гангрена тонкой кишки — у 57 (73 %), толстой — у 5 (6,4 %), тонкой и толстой кишки — у 16 больных (20,5%).
Тромбозы мезентериальных сосудов могут быть также осложнением пищевых токсикоинфекции. Нами наблюдались 33 подобных случая. Развитие указанного осложнения было обусловлено нарушениями микроциркуляции, преимущественно в посткапиллярах, артериолах и венулах. Экспериментальные исследования В.Д.Помойницкого и В.В.Титова (1984) с использованием сальмонеллезного токсина на животных показали усиленное образование тромбоцитарных и эритроцитарных агрегатов с тромбообразованием в системе микроциркуляции.
У наблюдавшихся нами больных атеросклеротические изменения в мезентериальных сосудах отсутствовали. Развитие тромбоза в мелких брыжеечных сосудах происходило чаще всего на 3—4-й день пищевой токсикоинфекции, преимущественно в тяжелой (66,6 %) и среднетяжелой (33,4 %) форме. При этом обезвоживание II степени отмечалось у 36,4 % и III степени у 63,6 % больных. Диагноз тромбоза мезентериальных сосудов был подтвержден на вскрытии (у 22 — мелких артериальных, у 2 — мелких венозных сосудов брыжейки).
Некроз тонкой кишки был выявлен у 78,8% умерших, толстой кишки - у 12,1 %, тонкой и толстой — у 9,1 %. При гистологических исследованиях во всех случаях наблюдались генерализованное расстройство микроциркуляции стенки кишки и сладж-феномен.
Итак, целесообразно различать два вида тромбоза мезентериальных сосудов: 1) тромбоз брыжеечных артерий, патогенетически связанный с атеросклерозом, гипертонической болезнью, и тромбоз брыжеечных вен, обусловленный чаще тромбофлебитом и эмболиями; 2) тромбоз мелких брыжеечных сосудов (капилляры, посткапилляры артериолы, венулы), связанный с гемодинамическими нарушениями, гемоконцентрацией, диссеминированным внутрисосудистым свертыванием (ДВС) и другими гомеостатическими нарушениями при тяжелом течении острых кишечных инфекций.
Дифференциальный диагноз указанных вариантов тромбоза мезентериальных сосудов сложный. Решающими моментами при этом являются учет анамнестических данных и динамика клинической картины болезни.
Информация на сайте подлежит консультации лечащим врачом и не заменяет очной консультации с ним.
См. подробнее в пользовательском соглашении.
Тромбоз мезентериальных сосудов. Клиника тромбоза мезентериальных сосудов
Острые нарушения мезентериального кровообращения наблюдаются преимущественно у лиц среднего и пожилого возраста. Основные виды нарушений — эмболия, тромбоз артерий, тромбоз вен, неокклюзионный. Различают три да течения болезни: 1) с последующей компенсацией кровотока; 2) с последующей субкомпенсацией кровотока; 3) с декомпенсацией кровотока. При нарушениях с декомпенсацией мезентериального кровообращения формируется инфаркт кишечника.
Неокклюзионные нарушения мезентериального кровообращения происходят на уровне микроциркуляторного русла кишечной стенки и могут возникать на Лоне острых кишечных инфекций, шока, инфаркта миокарда и др. В части случаев наблюдается сочетание окклюзионных и неокклюзионных механизмов нарушений мезентериального кровообращения. Локализация и протяженность инфаркта кишечника обусловлены видом нарушенного кровотока, калибром брыжеечного сосуда, уровнем окклюзии, развитием коллатеральных путей компенсации кровотока.
При локализации окклюзии в верхнем сегменте верхней брыжеечной артерии развивается тромбоз всей тонкой и толстой кишки справа. Если закупорка расположена в среднем или нижнем сегменте артерии, то тромбоз охватывает подвздошную и слепую кишку. Тромбоз нижней брыжеечной артерии приводит чаще к поражению ободочной и сигмовидной кишки. Тромбоз воротной и верхней брыжеечной вены сопровождается некрозом только тонкой кишки.
Клиническая картина болезни обусловлена стадией заболевания: I стадия (ишемия) — обратимая и характеризуется рефлекторными и гемодинамическими нарушениями; во II стадии (инфаркт) присоединяются интоксикация и локальные изменения брюшной полости; в III стадии (перитонит) отмечаются выраженная интоксикация, гемодинамические расстройства и перитонеальные явления.

Ангиография при мезентриальном тромбозе
По мнению Г.Ф. Ланга (1957) и Е.И.Чазова (1966), у некоторых больных до начала заболевания появляются предвестники, напоминающие предынфарктное состояние. Характерны приступы острой боли в области живота, возникающей время от времени наподобие кризов. Последние развиваются вследствие выраженного спазма сосудов брюшной полости и образования в них мелких тромбов. Такая "абдоминальная ангина", или "брюшная жаба", - предвестник обширной окклюзии брыжеечных сосудов.
Клиническая картина тромбоза мезентериальных сосудов заивисит от калибра и локализации закупоренного сосуда. Заболевание часто начинается остро и протекает бурно, однако возможно и постепенное его развитие Характерна интенсивная боль в области живота, часто невыносимая. Боль иногда бывает схваткообразной, He чаще носит постоянный характер. Локализация боли часто неопределенная. Развитие артериального тромбоза мезентериальных сосудов происходит в течение 1 сут венозный тромбоз формируется более медленно — в течение 2—5 дней.
Довольно рано возникает рвота. В 1-е сутки в рвотных массах видна примесь желчи. Позднее рвота приобретает каловый запах. При тромбозе верхней брыжеечной артерии в рвотных массах имеется примесь крови. Однако рвота при тромбозе мезентериальных сосудов не бывает столь частой и обильной, как при пищевой токсикоинфекции; стул нередко становится жидким, что обусловлено бурной перистальтикой кишечника в начальном периоде болезни.
Во 2-м периоде болезни понос сменяется запором в результате глубоких деструктивных изменений в стенке кишечника. Нередко при тромбозе нижней брыжеечной артерии в кале имеется примесь крови, однако массивные кишечные кровотечения для тромбоза мезентериальных сосудов не характерны. Иногда могут наблюдаться тенезмы, что нередко симулирует острую дизентерию. Скопление крови в петлях кишечника может привести к появлению тестообразной припухлости между пупком и лобком (симптом Мондора).
Иногда болевой синдром сопровождается развитием шока. Этому способствует перемещение значительной части крови в сосуды брюшной полости. Очень показательно поведение больных: они кричат от боли, просят оказать им помощь, не находят себе места. При осмотре отмечаются резкая бледность кожного покрова, цианоз. При высоких окклюзиях верхней брыжеечной артерии АД повышается на 60—80 мм рт.ст. (симптом Блинова), иногда определяется брадикардия. В стадии инфаркта отмечается уменьшение боли в области живота, поведение больных становится более спокойным. Рвота продолжается, стул жидкий лишь У половины больных, у остальных — запор.
Живот при пальпации умеренно вздут, мягкий, болезненность выражена неярко, мышечная защита отсутствует, симптом Щеткина отрицательный, однако на этом фоне происходит быстрое нарастание лейкоцитоза периферической крови (20,0—40,0*10 9 /л). Спустя несколько часов в соответствии с зонами инфаркта кишечника появляется локальная болезненность при пальпации живота. Развивается перитонит, имеющий ряд особенностей:
- более позднее возникновение мышечной защиты;
- более позднее появление симптома Щеткина;
- воспалительный процесс, как правило, начинается внизу;
- понос сменяется задержкой стула и газов из-за пареза кишечника.
Частота мезентерального тромбоза. Клиника
Различают окклюзионную и неокклюзионную мезентериальную ишемию. Окклюзионный тромбоз. Наиболее частой причиной острой абдоминальной ишемии, по нашим данным, у 72% больных пожилого и старческого возраста служит тромбоз устья верхней брыжеечной артерии на месте ее сужения. У 16% отмечается тромбоз кишечных сегментарных ветвей верхней брыжеечной артерии, вызывая сегментарную гангрену тонкой кишки. У 6% отмечен венозный тромбоз (3% сегментарный, 3% тотальный). У остальных 4% имелся сочетанный и артериальный и венозный тромбоз.
Неокклюзионная мезентериальная ишемия встречается в 20—30% из случаев острой ишемии кишечника, и при этом виде нарушения кровотока летальность достигает 50%.
В основе такого поражения лежит гипоперфузия стенки кишечника, причины которой могут быть различными. Одной из основных причин неокклюзионной ишемии кишечника считают ангиоспазм на уровне артериол, который, как правило, сопровождается спазмом вен, замедлением кровотока в них и, если имеется состояние гиперкоагуляции, то возникает так называемый пристеночный тромбоз. Ангиоспазм возникает при заболеваниях сердечно-сосудистой системы с развитием ее недостаточности, при низком сердечном выбросе.
Диагностика неокклюзионного тромбоза основывается на магнитно-ядерном резонансе, спиральной КТ с контрастирующим веществом, при котором диагноз неокклюзионного тромбоза устанавливается в 90%, однако в неотложной абдоминальной хирургии эти методы диагностики широко не используются. При ранней диагностике таких изменений рекомендуют внутриартериальное введение вазодилататоров в течение нескольких дней, а также раннее применение антикоагулянтов, и в дальнейшем оперативное лечение может не потребоваться.
Клиническая картина и течение острого нарушения мезентериального кровообращения вариабельны и зависят от вида, уровня, быстроты окклюзии и начала появления симптомов заболевания. Основной симптом при острой ишемии — боль в животе. Характер боли может быть от умеренно выраженной, медленно нарастающей до внезапной и сильной.
Признаки острого живота: вздутие, напряжение, лихорадка, рвота, гипотензия встречается, но уже при поздних стадиях. Течение заболевания обусловлено временем появления.
При окклюзии сосудов брыжейки выделяют 3 стадии заболевания:
1-я — стадия ишемии, которая начинается сразу же после возникновения окклюзии и продолжается от 6 до 12 часов.
2-я — стадия инфаркта, 12—48 часов.
3-я — стадия перитонита.

У лиц старше 60 лет нередко заболеванию предшествуют различной выраженности приступы «брюшной жабы»: периодически появляющиеся боли в животе, тошнота, рвота, метеоризм, нарушение функции желудочно-кишечного тракта, потеря в массе тела. Боли связаны с приемом пищи, и больные стараются не есть.
Общее состояние больных уже при поступлении, как правило, тяжелое и обусловлено заболеванием, на фоне которого развивалось нарушение мезентериального кровообращения, гемодинамическими нарушениями, коллапсом, а в стадии некроза кишки — перитонитом и интоксикацией.
Общий вид и поведение больного характерны для тяжело страдающего: бледность кожных покровов с землисто-серым оттенком, липкий пот, акроцианоз. Поведение беспокойное, больной может метаться, менять положение тела, стонет и даже кричит от болей. При прогрессировании заболевания состояние ухудшается, больной становится менее активным, утихает, принимает вынужденное положение на спине или на боку с подтянутыми к животу конечностями.
Осмотр больного начинают с языка. У больного с мезентериальным тромбозом в начале заболевания язык мал отмененный, по мере прогрессирования заболевания с развитием перитонита и интоксикации язык становится сухим, покрывается налетом.
Пульс изменяется соответственно клинической картине. При остром начале заболевания пульс становится частым, слабого наполнения.
Артериальное давление при тромбозе и эмболии мезентериальных сосудов в самом начале заболевания повышенное, что является характерным, и быстро снижается при развитии заболевания. Повышение артериального давления объясняется спазмом сосудов кишечника, который рефлекторно распространяется на всю артериальную систему.
Изменения температуры тела не имеют закономерности. В начале заболевания температура тела в пределах нормы, если нет причин для ее повышения (гнойные заболевания, тромбофлебиты и др.). При развитии интоксикации и перитонита температура может быть ниже нормы.
Объективные данные при осмотре живота зависят от стадии заболевания. В начальном периоде конфигурация живота обычно не изменена, живот в дыхании участвует. При развитии патологического процесса появляется вздутие, которое постепенно прогрессирует. При закупорке сосудов брыжейки характерно умеренное вздутие, без заметной перистальтики.
При пальпации живота болезненность возникает до развития воспалительных изменений в брюшной полости.
Как правило, в начале заболевания определяется мягкая, малоболезненная брюшная стенка, без напряжения мышц, что не соответствует общему состоянию больного, который страдает от невыносимых болей в животе. Через несколько часов появляется резкая болезненность по всему животу, но наиболее выраженная в месте пораженной кишки, и напряжение мышц передней брюшной стенки. В стадии развивавшегося перитонита имеется выраженная болезненность по всему животу и положительные симптомы разлитого перитонита.
Исследование прямой кишки может дать ценные сведения для диагностики нарушения кровоснабжения кишечника. При пальцевом исследовании на перчатке можно обнаружить кровь, нависание стенки кишки в дугласовом пространстве. Характерным для мезентериального нарушения кровотока является примесь крови в стуле, степень выраженности которой различна: от небольших следов в виде мазков при пальцевом исследовании до значительной примеси. Мелена встречается в 15%, скрытое кровотечение — почти у половины больных.
Продолжительность болезни также более длительная. В то время как артериальный инфаркт обычно заканчивается смертью больного через 1—2 суток, при застойном инфаркте смерть наступает через 5—6 дней и позже.
Как одну из клинических особенностей острого нарушения мезентериального кровообращения следует отметить двухэтапное развитие болезни. После типичного острого начала боли стихают на несколько дней, а затем состояние больного вновь резко ухудшается с развитием характерного болевого синдрома.
Диагностика нарушений мезентериального кровообращения сложна. Клиническая картина напоминает многие острые заболевания органов брюшной полости, а также некоторые инфекционные болезни.
Редактор: Искандер Милевски. Дата обновления публикации: 18.3.2021
Острый мезентериальный тромбоз
Мезентериальный тромбоз - это острое нарушение кровообращения в брыжеечных сосудах, возникающее вследствие эмболии или тромбоза брыжеечных артерий и вен. Распространенность мезентериального тромбоза. При мезентериальном тромбозе чаще всего поражается верхняя брыжеечная артерия (85-90%), намного реже поражается нижняя брыжеечная артерия (10-15%).
Данное заболевание встречается у мужчин и женщин примерно с одинаковой частотой. Тромбоз и эмболия мезентериальных сосудов развивается преимущественно в среднем и пожилом возрасте.
Этиология мезентериального тромбоза. Главными причинами развития мезентериального тромбоза являются заболевания сердца, приводящие к образованию тромбов - инфаркт миокарда, ревматические пороки, нарушения ритма, кардиосклероз, эндокардит. Кроме того очень часто к эмболии брыжеечных артерий приводит атеросклероз, при котором на стенках артерий образуются атеросклеротические бляшки. При отрыве этих бляшек возможна эмболия мезенетериальных артерий. Тромбоз мезентериальных вен возникает при портальной гипертензии, наличии гнойных процессов в брюшной полости (пилефлебит), сепсисе, травмах, сдавлении сосудов новообразованиями.
Клинические проявления мезентериального тромбоза.
1. Первым симптомом тромбоза и эмболии мезентериальных сосудов является резкая, интенсивная боль. Локализация болей зависит от уровня поражения брыжеечных сосудов. При поражении основного ствола верхней брыжеечной артерии боли чаще всего определяются в области. При поражении подвздошно-ободочной артерии боли локализуются в правой подвздошной области. В этом случае мезентериальный тромбоз необходимо дифференцировать с острым аппендицитом. При тромбозе и эмболии нижней брыжеечной артерии характерно появление болей в левой подвздошной области. Боли при данной патологии чаще всего постоянные, имеют интенсивный характер. Иногда боли имеют схваткообразный характер. В этом случае мезентериальный тромбоз можно спутать с острой кишечной непроходимостью, или же с кишечной коликой.
2. Вторым по частоте симптомом у больных с мезентериальным тромбозом является тошнота, иногда переходящая в рвоту. Тошнота и рвота встречается более чем у 50% больных с данной патологией.
3. При мезентериальном тромбозе возможен жидкий стул, иногда с примесью крови.
4. Тахикардия.
5. В начале заболевания температура тела будет нормальной. При развитии некроза кишечника температура может повышаться до 38 и более градусов.
6. По мере развития заболевания начинает развиваться клиническая картина паралитической кишечной непроходимости. При этом будет наблюдаться вздутие живота, отсутствие перистальтики, задержка стула, возможна рвота.
Лечение мезентериального тромбоза.
Необходимо помнить, что развитие мезентериального тромбоза угрожает жизни больного. Поэтому, чем раньше будет поставлен правильный диагноз, тем больше шансов спасти жизнь больному.
Наиболее целесообразно применение хирургической тактики лечения. Опреция проводится под эндотрахеальным наркозом. При отсутствии некроза кишечника возможно применение эндартерэктомии, эмболэктомии, протезирования брыжеечных артерий. В случае запущенности процесса развивается некроз кишечника, и в этом случае необходимо выполнить резекцию некротизированного участка кишки.
В качестве консервативной терапии применяется:
1. Парентеральное введение антикоагулянтов (Гепарин). Антикоагулянтную терапию необходимо проводить под контролем МНО, протромбинового индекса.
2. Парентеральное введение дезагрегантов (Реополиглюкин, Трентал, Гемодез)
Прогноз при мезентериальном тромбозе.
Летальность при этом заболевании может достигать 70-90%.
Некроз тонкого кишечника при остром тромбозе верхней брыжеечной артерии. Операция по резекции прожженного участка.
Читайте также:
- Причины апластической анемии - конституционная апластическая анемия Фанкони
- Диагностика стероидных гормонов. Методы
- Рентгенограмма, КТ, МРТ при ревматоидном артрите плечевого и локтевого суставов
- Признаки и диагностика стеноза гортани и трахеи
- Контрастная эхокардиография по поводу гипертрофической кардиомиопатии (ГКМП)
